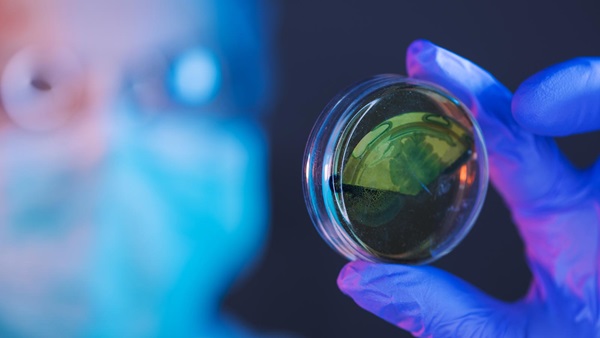
efectividad antibióticos

Resistencia antibiótica: un grave problema
El abuso y mal uso de los antibióticos da lugar a un aumento en las resistencias. La resistencia a los antibióticos es, de hecho, cada vez mayor, lo que perjudica gravemente la efectividad de estos fármacos. Contar con datos transparentes y veraces sobre este asunto es prioritario para la salud de todos.
Un problema real
La resistencia a los antibióticos ocurre cuando los antibióticos que usamos para curar las infecciones causadas por bacterias dejan de ser efectivos, ya que las bacterias cambian y se vuelven resistentes a ellos. El aumento de bacterias resistentes hace que sea complicado tratar muchas infecciones, con la consiguiente carga de mortalidad.

La Organización Mundial de la Salud (OMS) realizó una encuesta y recordó que, “el uso excesivo e indebido de los antibióticos aumenta el desarrollo de bacterias resistentes”. En esta encuesta, el 64% de las personas entrevistadas eran conscientes de que este problema afectaba tanto a sus familias como a ellos mismos. El problema, es que no entendían del todo bien cómo les afectaba, ni que hacer para evitarlo. Un 32% piensa que la solución es dejar el antibiótico cuando empiezas a sentirte mejor, en lugar de acabar el tratamiento.
Los hospitales no se libran
Las resistencias antibióticas son también un grave problema en los hospitales. Unas enterobacterias productoras de enzimas resistentes a los más potentes antibióticos han hecho saltar todas las alarmas: estas bacterias ya se registran en España en un gran número de hospitales.
Además, en los hospitales, casi la mitad de pacientes hospitalizados reciben antibióticos. Sin embargo, según advierte el Ministerio de Sanidad, entre el 40 y el 50% de las prescripciones de antibióticos realizadas en servicios de Atención Primaria y hospitalaria son “inadecuadas”. En consecuencia, en el Plan Nacional se han consensuado indicadores cuantitativos y cualitativos para la recogida de datos de consumo de antibióticos, la estructura de equipos de optimización de uso de antibióticos en hospitales…
En España desde hace tiempo ya en la mayor parte de los hospitales de diferentes comunidades autónomas se vienen desarrollando sistemas de vigilancia de la infección nosocomial (las infecciones hospitalarias) con especial incidencia en las infecciones por microorganismos de especial interés o multirresistentes.
Queremos información y transparencia
Es importante que los usuarios del sistema de salud conozcan cuáles son las medidas implementadas en su hospital para prevenir las infecciones bacterianas y cuáles son los planes que tienen en vigencia sobre uso prudente de los antibióticos. Así lo hemos solicitado en otras ocasiones.

Para OCU, el conocimiento y divulgación de los programas y medidas puestos en marcha en cada hospital, así como los resultados obtenidos:
- fomentan la adherencia a las buenas prácticas,
- ayudan a formar a los pacientes y usuarios y a los propios profesionales,
- contribuye a mejorar la calidad de los cuidados.
A lo largo de los últimos años, OCU ha llevado a cabo una campaña a favor de la transparencia hospitalaria, que ha contado con el apoyo de miles de usuarios. La damos por concluida con el fin de año, pero con el compromiso de seguir luchando por una información transparente que permita a los usuarios elegir con real conocimiento de causa.
Un problema real
La resistencia a los antibióticos ocurre cuando los antibióticos que usamos para curar las infecciones causadas por bacterias dejan de ser efectivos, ya que las bacterias cambian y se vuelven resistentes a ellos. El aumento de bacterias resistentes hace que sea complicado tratar muchas infecciones, con la consiguiente carga de mortalidad.
La Organización Mundial de la Salud (OMS) realizó una encuesta y recordó que, “el uso excesivo e indebido de los antibióticos aumenta el desarrollo de bacterias resistentes”. En esta encuesta, el 64% de las personas entrevistadas eran conscientes de que este problema afectaba tanto a sus familias como a ellos mismos. El problema, es que no entendían del todo bien cómo les afectaba, ni que hacer para evitarlo. Un 32% piensa que la solución es dejar el antibiótico cuando empiezas a sentirte mejor, en lugar de acabar el tratamiento.
Los hospitales no se libran
Las resistencias antibióticas son también un grave problema en los hospitales. Unas enterobacterias productoras de enzimas resistentes a los más potentes antibióticos han hecho saltar todas las alarmas: estas bacterias ya se registran en España en un gran número de hospitales.
Además, en los hospitales, casi la mitad de pacientes hospitalizados reciben antibióticos. Sin embargo, según advierte el Ministerio de Sanidad, entre el 40 y el 50% de las prescripciones de antibióticos realizadas en servicios de Atención Primaria y hospitalaria son “inadecuadas”. En consecuencia, en el Plan Nacional se han consensuado indicadores cuantitativos y cualitativos para la recogida de datos de consumo de antibióticos, la estructura de equipos de optimización de uso de antibióticos en hospitales…
En España desde hace tiempo ya en la mayor parte de los hospitales de diferentes comunidades autónomas se vienen desarrollando sistemas de vigilancia de la infección nosocomial (las infecciones hospitalarias) con especial incidencia en las infecciones por microorganismos de especial interés o multirresistentes.
Queremos información y transparencia
Es importante que los usuarios del sistema de salud conozcan cuáles son las medidas implementadas en su hospital para prevenir las infecciones bacterianas y cuáles son los planes que tienen en vigencia sobre uso prudente de los antibióticos. Así lo hemos solicitado en otras ocasiones.

Para OCU, el conocimiento y divulgación de los programas y medidas puestos en marcha en cada hospital, así como los resultados obtenidos:
- fomentan la adherencia a las buenas prácticas,
- ayudan a formar a los pacientes y usuarios y a los propios profesionales,
- contribuye a mejorar la calidad de los cuidados.
A lo largo de los últimos años, OCU ha llevado a cabo una campaña a favor de la transparencia hospitalaria, que ha contado con el apoyo de miles de usuarios. La damos por concluida con el fin de año, pero con el compromiso de seguir luchando por una información transparente que permita a los usuarios elegir con real conocimiento de causa.